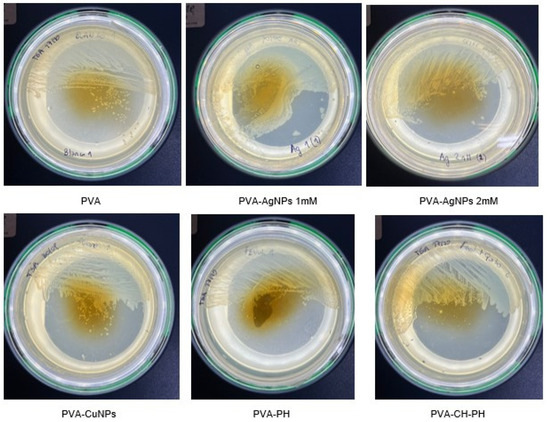

Abstract
The objective of this work was to formulate PVA films with the addition of modified phenols, chitosan, silver, or copper nanoparticles with fungistatic and bacteriostatic activity. The films were characterized by Fourier transform infrared spectroscopy, thermogravimetry analysis, differential scanning calorimetry, and scanning electron microscopy. The bacteriostatic activity against Salmonella gallinarum and Lactobacillus acidophilus, and the fungistatic activity against Penicillium acidophilus were determined. The results indicated that the addition of phenols enhanced the effect on the stability of the chemical structure of the PVA film. PVA films with modified bioactives and nanoparticles inhibited the colonization of the microorganisms tested, indicating germicidal control.
1. Introduction
Worldwide, numerous efforts are being made to reduce the use and environmental impact of petroleum-derived plastics, which has led to an increase in research aimed at obtaining biodegradable materials with special functionalities that allow their use in different sectors, such as environmental, food, medicine, and agriculture, among others [1].
The raw materials derived from renewable resources are biodegradable. The materials used for the formation of biodegradable films are mainly composed of cellulose, chitosan, starch, dextrins, alginates, and pectins [2,3,4,5]. In general, films made from biopolymers are sensitive to environmental conditions, especially relative humidity, and have low mechanical strength even when protein films have high elasticity [6]. A possible alternative to improve the mechanical characteristics of protein-based films could be the mixture of these biopolymers with synthetic polymers, such as polyvinyl alcohol (PVA), which is hydrophilic and biodegradable [7]. Some studies on the development and characterization of films based on mixtures of PVA and proteins, such as PVA/wheat gluten [8], PVA/hydrolyzed collagen [9], and PVA/gelatin [10], among others.
In the area of food packaging, it is very important to preserve the food quality and nutritional value for consumer safety [11]. Recently, it has been proposed to incorporate different nanomaterials and bioactive compounds into edible films to improve the film’s physico-chemical, mechanical, and thermal characteristics and provide other properties such as antimicrobial films without causing environmental problems [12,13].
Metallic nanoparticles (MNPs) constitute a special and particularly valuable group of nanoparticles (NPs) with interesting properties in the protection, preservation of food, and extension of the shelf life of food [14,15,16,17]. Other bioactives like polyphenols from lignins and tannins constitute a special valuable group of micro- and nanoparticles (NPs) with interesting properties in the protection and preservation of food, among other applications [1,15,16,18,19,20,21].
Chitosan (CHT) is recognized for its effective germicidal action, with a broad microbial spectrum and low toxicity in animals and humans [22,23]. The polycationic structure of chitosan plays a fundamental role in electrostatic fixation and bacterial deactivation. The bactericidal activity of functionalized chitosan films combined with polyvinyl alcohol has been reported [7]. Regarding the capacity of antifungal activity, it suppresses sporulation and germination, inhibiting its growth [7,23].
The objective of this work is to formulate different films based on PVA functionalized with different bioactives (CHT and phenols), AgNPs, and CuNPs. The morphological, physical-chemical, and thermal properties and germicidal activity of the films were evaluated. The germicidal properties in microorganisms were evaluated, which are found in greater proportion in the daily environment and in some pathogens that affect food without adequate conservation.
2. Materials and Methods
2.1. Materials
The materials used were glutaraldehyde and spam 80 from drogueria Paysandu (Uruguay) and polyvinyl alcohol (PVA) from Acros Organics (USA). The chitosan 1% p/v, AgNPs, CuNPs, and phenols were supplied from the Nuclear Research Center, Faculty of Science, University of the Republic.
2.2. Preparation of PVA Films
First, 10 mL of 10% PVA solution was prepared and dissolved in water, and then 1 mL of Spam 80 was added with vigorous agitation. Subsequently, 8 mL of glutaraldehyde was slowly added (dropwise) with continuous agitation. The solutions were cast on a Petri dish and maintained under constant agitation for 48 h at room temperature until solidification. Then, 0.5 mL of AgNPs (1 mM and 2 mM), CuNPs (1 mg/mL), chitosan NPs (1 mg/mL), and phenol NPs (2 mg/mL) were added in order to increase the germicidal properties of the PVA films. The codes and descriptions are given in Table 1.

Table 1.
Film sample codes and descriptions.
2.3. Films Characterization
2.3.1. Scanning Electron Microscopy
The films were analyzed using a scanning electron microscope (JSM-6390LV, Jeol, LANOTEC, San Jose, Costa Rica), with a voltage acceleration of 10 kV, secondary electrons (SEI), and a spot size of 40. Images were taken at different magnifications to identify the morphology of the films.
2.3.2. Fourier-Transform Infrared Spectroscopy
FTIR spectra of the films were recorded using an FTIR Nicolet 6700 spectrophotometer with a diamond ATR module (Thermo Fisher Scientific, Miami, FL, USA) in the number range waveform from 4000 to 500 cm−1 with a standard resolution of 4 cm−1 and a scanning speed of 32 cm−1/s. The results were analyzed using the OMNIC 8.1 software (OMNIC Series 8.1.10, Thermo Fisher Scientific).
2.3.3. Thermogravimetric Analysis
The films were analyzed via thermogravimetric analysis (TGA) TGA-Q500 (TA Instruments, Philadelphia, PA, USA) equipped with Universal Analysis 2000 software (version 4.5A, TA Instruments, USA). Approximately 5 mg of the sample was used for the TGA analyses, with a temperature ramp of 10 °C/min from 25 to 800 °C under nitrogen (flow rate 90 mL/min).
2.3.4. Differential Scanning Calorimetry
Differential scanning calorimetry (DSC) was performed using the DSC Q200 equipment, TA Instruments (USA). The samples were analyzed in duplicate using a ramp that covered a cycle from 25 °C to 400 °C, with a heating rate of 10 °C/min and a nitrogen flow of 10 mL/min. The data obtained were analyzed using the TA Universal Analysis software (Advantage Software v5.5.24).
2.4. Determination of Control of Environmental Microorganisms
2.4.1. Determination of Bacteriostatic Activity against Lactobacillus
For the test, pure cultures of Lactobacillus acidophilus were maintained in 10 mL of liquid medium with 20% w/v glucose and 7% w/v yeast extract in a 50 mL flask. The pH was adjusted to 5.5. Then, it was incubated at 30 °C for 48 h without shaking. Subsequently, 0.1 mL of the inocula was plated on Petri dishes with solid culture medium MRS and films (PVA, PVA-PH, PVA-CH-PH, PVA-AgNPs, and PVA-CH-CuNPs) of 2 × 2 cm were incubated in an oven at 33 °C. The bacterial growth was monitored at 24 and 48 h (n = 2).
2.4.2. Determination of Bacteriostatic Activity against Salmonella gallinarum
A reconstituted Salmonella gallinarum strain was used for this determination. The bacteria were cultured at 37 °C for 24 h. Then, 10 μL of the inocula was plated in Petri dishes containing TSA culture medium. Subsequently, seeding was spread from one end to the middle of the plate surface. Then, a piece of membrane 2 × 2 cm in diameter (PVA, PVA-PH, PVA-CH-PH, PVA-AgNPs, and PVA-CH-CuNPs) was placed in the center of the plate and incubated in an oven at 37 °C. The bacterial growth was monitored until the 7th day post-incubation.
2.4.3. Determination of Fungistatic Activity against Penicillium
For the test, pure cultures of Penicillium sp. were maintained in 10 mL of liquid medium with 20% w/v glucose and 7% w/v yeast extract in a 50 mL flask. The pH was adjusted to 6.0. Then, it was incubated at 37 °C for 7 days under shaking. Subsequently, 0.1 mL of the inocula was plated on Petri dishes containing solid culture medium MRS and films (PVA, PVA-PH, PVA-CH-PH, PVA-AgNPs, and PVA-CH-CuNPs) of 2 × 2 cm and incubated at 33 °C. The fungal growth was monitored on days 5, 7, and 10 (n = 2). Some photographs were taken to illustrate the effect.
3. Results and Discussion
3.1. Films Characterization
The morphology of the films (PVA, PVA-PH, PVA-CH-PH, PVA-AgNPs, and PVA-CuNPs) were analyzed using SEM (Figure 1). The morphology of the surface and cross-section of the PVA films was smooth with some pores between 5 and 20 µm and a thickness of 110 µm. The PVA-PH film had a rough surface with pores between 20 and 100 µm and a thickness of 200 µm. Otherwise, the PVA-CH-PH film had a smooth surface with pores between 1 and 25 µm and a thickness of 100 µm. The PVA-AgNPs film presented a rough surface with microparticles in the presence of pores with sizes between 1 and 15 µm; this film had a thickness of 150 µm. Similar to the PVA-AgNPs, the PVA-CuNPs film presented a rough surface with microparticles between 5 and 20 µm on the surface, and the thickness of this film was 50 µm.

Figure 1.
SEM surface (a,c,e,g,i) and cross-sectional (b,d,f,h,j) images of (a,b) PVA, (c,d) PVA-PH, (e,f) PVA-CH-PH, (g,h) PVA-AgNPs, and (i,j) PVA-CuNPs.
3.1.1. Fourier Transform Infrared Spectroscopy Analysis
FTIR-ATR analysis was carried out to study the molecular interaction between CH, PVA, AgNPs, CuNPs, and natural phenols in the films.
Figure 2 shows the FTIR spectrum of the PVA-based polymeric film samples, where it was possible to observe a broad absorption band at 3014–3680 cm−1 that was attributed to the stretching vibration of OH groups, which may be due to the presence of hydroxyl groups and residual moisture content of PVA films [24,25]. On the other hand, the nearby bands at 2920 and 2854 cm−1 were attributed to the asymmetric and symmetric stretching of the CH and CH2 groups, respectively. In addition, a peak was observed at 1740 cm−1, which was due to the stretching of the C-O group [3].

Figure 2.
FTIR spectra of PVA, PVA-AgNPs, PVA-CH-PH, PVA-CuNPs, and PVA-PH films.
The peaks at 1563 cm−1 are designated as the stretching vibrations of the C=O group, while the peaks near 1420, 1370/1330/1242, 1086, and 838 cm−1 are attributed to the in-plane bending of the OH, the bending of the CH group, and the stretching of the C-O and CH of the PVA, respectively [11,25,26,27,28]. In addition, an absorption peak was observed at 1142 cm−1 in the long band between 1085 and 1150. According to the literature, this vibrational band is mainly attributed to the PVA crystallinity, which is related to the carboxyl (C-O) stretch band [24,29,30]
According to the results, it was clearly observed that the main peaks of the spectra are mainly associated with polyvinyl alcohol. This is due to the high concentration of this material, which is the polymeric matrix of the films, depending on the other components present. However, the bands at 1420–1375, 1085–1150, and 838 cm−1, which are also characteristic of chitosan, may be interposed with those of PVA. In this case, for chitosan, these bands are attributed to the symmetric deformations of the CH2 and CH3 groups, the stretching vibrations of the C–O–C groups characteristic of polysaccharides, and the amine groups of chitosan, respectively [31,32,33].
3.1.2. Thermogravimetric Analysis
Figure 3 shows the TGA and derivative of TGA (DTG) of PVA-PH, PVA-CH-PH, PVA-AgNPs, and PVA-CuNPs films. All the films show similar curves with four steps of weight loss as a function of the increasing temperature. The first step between 25 and 125 °C corresponds to the evaporation of water [34]. The second step was the main degradation region at 150–350 °C due to the degradation of the exposed side chain and the breakdown of polymeric chains of PVA and chitosan [35]. The third weight loss (350–425 °C) corresponds to the oxidative decomposition of carbon residues, [35] and the final weight loss (425–500 °C) represents the decomposition to ash [27,34,36].

Figure 3.
TGA and DTG curves of (a) PVA, (b) PVA-AgNPs, (c) PVA-CH-PH, (d) PVA-CuNPs, and (e) PVA-PH films.
According to the thermal profiles of the samples, there are no significant differences in the thermogram curves. This indicates that the different additives applied in the formulations do not improve the thermal stability parameters. This is possibly associated with the low concentration of the additives and/or the low degradation temperature, which may be involved in the main PVA decomposition events.
3.1.3. Differential Scanning Calorimetry
Figure 4 shows the DSC curves of the PVA, PVA-AgNPs, PVA-CH-PH, PVA-CuNPs, and PVA-PH films as a function of temperature. The results showed endothermic events in different temperature ranges. The first is reported near 45 °C and corresponds to the glass transition temperature (Tg) of the PVA polymer [37]. On the other hand, events between 60 and 170 °C represent dehydration processes due to the evaporation of physically adsorbed water content [35]. Finally, the events that appear near 175–195 °C and 240–350 °C can be attributed to the melting point (Tm) and thermal pyrolysis of the PVA polymer, respectively, which agrees with what has been reported by other authors [27,38,39].

Figure 4.
DSC curves of PVA, PVA-AgNPs, PVA-CuNPs, PVA-PH, and PVA-CH-PH films.
According to the results, it was possible to observe a displacement of +10 °C in the thermal pyrolysis events for the PVA-PH film compared to the PVA film. This could be associated with the molecular interactions between PVA and phenols, which in turn have a more stable chemical structure.
3.2. Fungistatic and Bacteriostatic Activity
The results of bacteriostatic activity of the films against Lactobacillus showed that the PVA film presented moderate bacterial growth on the films; in the PVA-AgNPs films at a concentration of 1 mM and 2 mM, the bacterial growth was minimal and null, respectively. Similarly, in the PVA-CuNPs and PVA-PH, the growth was minimal at 2% and 1% of the plate, respectively. The highest inhibition activity was observed for the PVA-CH-PH film, where there was a synergy between the germicidal activity of the two compounds. It should also be mentioned that there was no invasion of the microorganism on the film in any of the cases, and there was actually an inhibition of growth (Figure 5).

Figure 5.
Culture and inhibition control of Lactobacillus sp. after 7 days of contact with PVA; PVA-AgNP 1 mM; A-AgNP 2 mM; PVA-CuNPs; PVA-PH; and PVA-CH-PH films.
We observed the growth inhibition of Salmonella in PVA-AgNPs 2 mM films, whereas, in PVA-AgNPs 1 mM films, total bacterial growth on the film was observed. The antibacterial activity of the nanocomposite films was also investigated against Salmonella typhimurium using the disk diffusion method. The results showed that the PVA film has excellent antibacterial activity against Salmonella typhimurium, as reported in other works [40,41]. In the PVA-PH and PVA-CH-PH films, we determined the growth inhibition of Salmonella sp., whereas, in the case of the PVA-CuNPs film, the growth was over the entire edge of the film (Figure 6).
Figure 6.
Culture and inhibition control of Salmonella after 7 days of contact with PVA; PVA-AgNPs 1 mM; PVA-AgNPs 2 mM; PVA-CuNPs; PVA-PH; PVA-CH-PH films.
Other authors determined the antibacterial and antifungal activities of nanocomposite PVA films [40] and PVA-Starch film with the addition of oregano essential oil [42]. Moreover, the microbial activity of the films with the addition of AgNPs was determined in films with the addition of these NPs [40,43]. In addition, chitosan was used due to its germicidal activity in PVA films [40].
The results of the fungistatic activity against Penicillium sp. (Figure 7) showed that in all the treatments, there was no fungal growth on the culture media or film after 7 days of incubation. The cultures were kept under study for a longer time to test resistance and control over time. The behavior at 21 days showed a slight minimum growth in the PVA film, whereas in the others, the growth did not manifest.

Figure 7.
Culture and inhibition control of Penicillium after 7 days of contact with PVA; PVA-AgNP 1 mM; PVA-AgNP 2 mM; PVA-CuNPs; PVA-PH; and PVA-CH-PH films.
The fungistatic and bacteriostatic activity of the phenols incorporated in the PVA-PH films developed in this research had similar behavior to that reported by other authors [44], who found antimicrobial activity in films using bioactives such as phenols of plant extracts and propolis, without being incorporated into films. This form of direct application of bioactives produces diffusion, which produces inhibitory activity by halo production.
It has been determined in the literature that phenolic compounds such as phenol, hexachlorophenol, and thymol present an intermediate level of disinfection, and their activity is closely related to the concentration and the microbial species to be treated. Their mechanism of action is via the disruption of the cell wall and membrane and inactivation of enzyme systems. Moreover, Abud-Blanco et al. [19] determined that films with sulfonated phenolic compounds showed antibacterial activity against Enterococcus feacalis. Otherwise, tannins obtained from plant extracts were reported as antimicrobial agents for both Gram-positive bacteria such as Listeria monocytogenes and Staphylococcus aureus, and Gram-negative bacteria Escherichia coli and Salmonella enterica Serovar Typhimurium [45].
Other authors [18] described the germicidal properties of propolis and its phenolic components, like caffeic acid, ferulic acid, isoferulic acid, 3,4-dimethoxycinnamic acid, pinobanksin, caffeic acid benzyl ester, and caffeic acid phenethyl ester, which present antimicrobial properties and inhibitory effect on different bacteria such as E. coli, Lactobacillus plantarum, S. aureus, S. epidermidis, Pseudomonas aeruginosa, P. fluorescens, Listeria monocytogenes, L. innocua, Klebsiella pneumoniae, Salmonella typhimurium, S. enteritidis, Streptococcus agalactiae, S. mutans, Bacillus cereus, B. subtilis, Citrobacter freundii, Enterobacter aerogenes, Shigella dysenteriae, Yersinia enterocolitica, and Pantoea agglomerans.
The antimicrobial tests carried out on the PVA-CuNPs film showed an inhibition since the bacterial strains did not grow on the film. They reach the edge in some cases or present an inhibition halo of about 2 mm. Other studies in which the NPs were used directly were reported by the authors of [17], who observed inhibition halos of the positive control for Staphylococcus epidermidis, Aerococcus viridans, Ochrobactrum anthropi, and Micrococcus lylae with diameters of inhibition of 21, 18, 7, and 19 mm, respectively, whereas for the negative control, the diameters of inhibition were 6 mm for all the bacteria studied. Many researchers affirm that the essential mechanism for the cytotoxicity generated by NPs is the release of Cu2+ ions that react with the thiol (SH) groups of the proteins present on the surface of the bacterial cell membrane. These proteins protrude from the cell membrane, allowing the transport of nutrients through the cell wall. The NPs can inactivate these proteins, thereby reducing the membrane permeability and causing cell death [17].
It is important to emphasize that none of the developed films grew microorganisms on the film, which indicates that the bioactives and NPs added to the PVA films had great germicidal control over the microorganisms studied. Future work on the study of other genera of microorganisms that are present in food or food packaging can be conducted, and it is also important to study the permanence of bioactives and NPs in the film since it would be desirable that they not be released in the food to be preserved.
4. Conclusions
The films obtained can be of different thicknesses, thin for coating, or of greater caliber for container food packaging. The methodology for obtaining films was adequate to obtain PVA membranes that are physically and chemically similar to each other and have a low production cost. The incorporation of phenolic, NPs, and chitosan bioactives into PVA showed a synergistic effect on antibacterial and fungicidal activity. Based on this study, the modified films that incorporate different bioactives can be applied as novel potential food packaging materials.
Author Contributions
M.L.: Conceptualization, methodology, investigation, resources, writing—original draft preparation, writing—review and editing, supervision, project administration, and funding acquisition; J.R.V.-B.: visualization, supervision, project administration, and funding acquisition; D.B.-M.: methodology, software, validation, writing—original draft preparation, writing—review and editing, visualization, and supervision; G.M.d.O.-V.: formal analysis, writing—original draft preparation, writing—review and editing, visualization, and supervision; J.M.Z.-U.: methodology, software, validation, formal analysis, writing—original draft preparation, and writing—review and editing. N.L.: formal analysis, visualization, writing—review and editing, and investigation. G.L.: methodology, investigation, software, validation, writing—original draft preparation, writing—review and editing, visualization, and supervision. All authors have read and agreed to the published version of the manuscript.
Funding
This research was funded by ENVABIO100 (Ref: 121RT0108).
Institutional Review Board Statement
Not applicable for studies not involving humans or animals.
Informed Consent Statement
Not applicable for studies not involving humans.
Data Availability Statement
Data sharing is not applicable to this article.
Conflicts of Interest
The authors declare no conflict of interest.
References
- Lopretti, M.; Lecot, N.; Rodriguez, A.; Lluberas, G.; Orozco, F.; Bolaños, L.; Montes De Oca, G.; Cerecetto, H.; Vega-Baudrit, J. Biorefinery of rice husk to obtain functionalized bioactive compounds. J. Renew. Mater. 2019, 7, 313–324. [Google Scholar] [CrossRef]
- Shiekh, K.A.; Liangpanth, M.; Luesuwan, S.; Kraisitthisirintr, R.; Ngiwngam, K.; Rawdkuen, S.; Rachtanapun, P.; Karbowiak, T.; Tongdeesoontorn, W. Preparation and characterization of bioactive chitosan film loaded with cashew (Anacardium occidentale) leaf extract. Polymers 2022, 14, 540. [Google Scholar] [CrossRef] [PubMed]
- Kochkina, N.E.; Lukin, N.D. Structure and properties of biodegradable maize starch/chitosan composite films as affected by PVA additions. Int. J. Biol. Macromol. 2020, 157, 377–384. [Google Scholar] [CrossRef]
- Rafique, A.; Mahmood Zia, K.; Zuber, M.; Tabasum, S.; Rehman, S. Chitosan functionalized poly(Vinyl alcohol) for prospects biomedical and industrial applications: A review. Int. J. Biol. Macromol. 2016, 87, 141–154. [Google Scholar] [CrossRef] [PubMed]
- Tharanathan, R.N. Biodegradable films and composite coatings: Past, present and future. Trends Food Sci. Technol. 2003, 14, 71–78. [Google Scholar] [CrossRef]
- Chen, H.; Wang, J.; Cheng, Y.; Wang, C.; Liu, H.; Bian, H.; Pan, Y.; Sun, J.; Han, W. Application of protein-based films and coatings for food packaging: A review. Polymers 2019, 11, 2039. [Google Scholar] [CrossRef]
- Annu; Ali, A.; Ahmed, S. Eco-friendly natural extract loaded antioxidative chitosan/polyvinyl alcohol based active films for food packaging. Heliyon 2021, 7, e06550. [Google Scholar] [CrossRef]
- DeButts, B.L.; Spivey, C.R.; Barone, J.R. Wheat gluten aggregates as a reinforcement for poly(Vinyl alcohol) films. ACS Sustain. Chem. Eng. 2018, 6, 2422–2430. [Google Scholar] [CrossRef]
- García-Hernández, A.; Morales-Sánchez, E.; Berdeja-Martínez, B.; Escamilla-García, M.; Salgado-Cruz Ma Rentería-Ortega, M.; Farrera-Rebollo, R.; Vega-Cuellar, M.; Calderón-Domínguez, G. Pva-based electrospun biomembranes with hydrolyzed collagen and ethanolic extract of hypericum perforatum for potential use as wound dressing: Fabrication and characterization. Polymers 2022, 14, 1981. [Google Scholar] [CrossRef]
- Damayanti, R.; Tamrin; Alfian, Z.; Eddyanto, E. Preparation film gelatin PVA/gelatin and characterization mechanical properties. AIP Conf. Proc. 2021, 2342, 060004. [Google Scholar] [CrossRef]
- Abedi-Firoozjah, R.; Chabook, N.; Rostami, O.; Heydari, M.; Kolahdouz-Nasiri, A.; Javanmardi, F.; Abdolmaleki, K.; Mousavi Khaneghah, A. PVA/starch films: An updated review of their preparation, characterization, and diverse applications in the food industry. Polym. Test. 2023, 118, 107903. [Google Scholar] [CrossRef]
- Vázquez-Luna, A.; Santiago, M.; Rivadeneyra-Domínguez, E.; Díaz-Sobac, R. Películas comestibles a base de almidón nanoestructurado como material de barrera a la humedad. CienciaUAT 2019, 13, 152. [Google Scholar] [CrossRef]
- Dey, D.; Dharini, V.; Periyar Selvam, S.; Rotimi Sadiku, E.; Mahesh Kumar, M.; Jayaramudu, J.; Nath Gupta, U. Physical, antifungal, and biodegradable properties of cellulose nanocrystals and chitosan nanoparticles for food packaging application. Mater. Today Proc. 2021, 38, 860–869. [Google Scholar] [CrossRef]
- Souza VG, L.; Alves, M.M.; Santos, C.F.; Ribeiro IA, C.; Rodrigues, C.; Coelhoso, I.; Fernando, A.L. Biodegradable chitosan films with zno nanoparticles synthesized using food industry by-products—Production and characterization. Coatings 2021, 11, 646. [Google Scholar] [CrossRef]
- Sayadi, M.; Mojaddar Langroodi, A.; Amiri, S.; Radi, M. Effect of nanocomposite alginate-based film incorporated with cumin essential oil and TiO 2 nanoparticles on chemical, microbial, and sensory properties of fresh meat/beef. Food Sci. Nutr. 2022, 10, 1401–1413. [Google Scholar] [CrossRef] [PubMed]
- Couto, C.; Almeida, A. Metallic nanoparticles in the food sector: A mini-review. Foods 2022, 11, 402. [Google Scholar] [CrossRef]
- Gómez León, M.M.; Román Mendoza, L.E.; Castro Basurto, F.V.; Maúrtua Torres, D.J.; Condori, C.; Vivas, D.; Bianchi, A.E.; Paraguay Delgado, F.; Solís Veliz, J.L. Nanopartículas de CuO y su propiedad antimicrobiana en cepas intrahospitalarias. Rev. Colomb. De Química 2017, 46, 28–36. [Google Scholar] [CrossRef]
- Fernández-León, K.J.; Rodríguez-Díaz, J.A.; Reyes-Espinosa, L.; Duquesne-Alderete, A.; Solenzal-Valdivia, Y.O.; Rives-Quintero, A.; Hernández-García, J.E. Comparison of in vitro anti- Staphylococcus aureus activity of eight antibiotics and four dilutions of propolis. J. Selva Andin. Res. Soc. 2022, 13, 35–48. [Google Scholar] [CrossRef]
- Abud Blanco, K.; Bustos Blanco, L.; Covo Morales, E.; Fang Mercado, L.C. Actividad antimicrobiana in vitro de compuestos fenólicos sulfonados en cavidad oral. Cienc. Y Salud Virtual 2015, 7, 53. [Google Scholar] [CrossRef]
- Heredia-Castro, P.Y.; García-Baldenegro, C.V.; Santos-Espinosa, A.; de Jesús Tolano-Villaverde, J.; Manzanarez-Quin, C.G.; Valdez-Domínguez, R.D.; Ibarra-Zazueta, C.; Osuna-Chávez, R.F.; Rueda-Puente, E.O.; Hernández-Moreno, C.G.; et al. Perfil fitoquímico, actividad antimicrobiana y antioxidante de extractos de Gnaphalium oxyphyllum y Euphorbia maculata nativas de Sonora, México. Rev. Mex. Cienc. Pecu. 2022, 13, 928–942. [Google Scholar] [CrossRef]
- Correa, M.L.; Alfaro, M.E.; Carballo, S.M.; Ureña, Y.C.; Vega-Baudrit, J. Estudio preliminar de la obtención de compuestos híbridos de quitosano y polifenoles derivados de lignina a partir de subproductos agropecuarios y pesquería de camarón. Rev. Científica 2017, 27, 33–43. [Google Scholar] [CrossRef]
- Kong, M.; Chen, X.G.; Xing, K.; Park, H.J. Antimicrobial properties of chitosan and mode of action: A state of the art review. Int. J. Food Microbiol. 2010, 144, 51–63. [Google Scholar] [CrossRef] [PubMed]
- Massana Roquero, D.; Bollella, P.; Katz, E.; Melman, A. Controlling porosity of calcium alginate hydrogels by interpenetrating polyvinyl alcohol–diboronate polymer network. ACS Appl. Polym. Mater. 2021, 3, 1499–1507. [Google Scholar] [CrossRef]
- Luque, G.C.; Picchio, M.L.; Martins, A.P.S.; Dominguez-Alfaro, A.; Tomé, L.C.; Mecerreyes, D.; Minari, R.J. Elastic and thermoreversible iongels by supramolecular pva/phenol interactions. Macromol. Biosci. 2020, 20, 2000119. [Google Scholar] [CrossRef] [PubMed]
- Patil, S.; Bharimalla, A.K.; Mahapatra, A.; Dhakane-Lad, J.; Arputharaj, A.; Kumar, M.; Raja AS, M.; Kambli, N. Effect of polymer blending on mechanical and barrier properties of starch-polyvinyl alcohol based biodegradable composite films. Food Biosci. 2021, 44, 101352. [Google Scholar] [CrossRef]
- Olewnik-Kruszkowska, E.; Gierszewska, M.; Jakubowska, E.; Tarach, I.; Sedlarik, V.; Pummerova, M. Antibacterial films based on pva and pva–chitosan modified with poly(Hexamethylene guanidine). Polymers 2019, 11, 2093. [Google Scholar] [CrossRef]
- Abral, H.; Ikhsan, M.; Rahmadiawan, D.; Handayani, D.; Sandrawati, N.; Sugiarti, E.; Muslimin, A.N. Anti-UV, antibacterial, strong, and high thermal resistant polyvinyl alcohol/Uncaria gambir extract biocomposite film. J. Mater. Res. Technol. 2022, 17, 2193–2202. [Google Scholar] [CrossRef]
- Aslam, M.; Raza, Z.A.; Siddique, A. Fabrication and chemo-physical characterization of CuO/chitosan nanocomposite-mediated tricomponent PVA films. Polym. Bull. 2021, 78, 1955–1965. [Google Scholar] [CrossRef]
- Mansur, H.S.; Oréfice, R.L.; Mansur, A.A.P. Characterization of poly(Vinyl alcohol)/poly(Ethylene glycol) hydrogels and PVA-derived hybrids by small-angle X-ray scattering and FTIR spectroscopy. Polymer 2004, 45, 7193–7202. [Google Scholar] [CrossRef]
- Okahisa, Y.; Matsuoka, K.; Yamada, K.; Wataoka, I. Comparison of polyvinyl alcohol films reinforced with cellulose nanofibers derived from oil palm by impregnating and casting methods. Carbohydr. Polym. 2020, 250, 116907. [Google Scholar] [CrossRef]
- Yasmeen, S.; Kabiraz, M.; Saha, B.; Qadir, M.; Gafur, M.; Masum, S. Chromium (Vi) ions removal from tannery effluent using chitosan-microcrystalline cellulose composite as adsorbent. Int. Res. J. Pure Appl. Chem. 2016, 10, 1–14. [Google Scholar] [CrossRef]
- Drabczyk, A.; Kudłacik-Kramarczyk, S.; Głąb, M.; Kędzierska, M.; Jaromin, A.; Mierzwiński, D.; Tyliszczak, B. Physicochemical investigations of chitosan-based hydrogels containing aloe vera designed for biomedical use. Materials 2020, 13, 3073. [Google Scholar] [CrossRef]
- Abu Elella, M.H.; Shalan, A.E.; Sabaa, M.W.; Mohamed, R.R. One-pot green synthesis of antimicrobial chitosan derivative nanocomposites to control foodborne pathogens. RSC Adv. 2022, 12, 1095–1104. [Google Scholar] [CrossRef] [PubMed]
- Tanwar, R.; Gupta, V.; Kumar, P.; Kumar, A.; Singh, S.; Gaikwad, K.K. Development and characterization of PVA-starch incorporated with coconut shell extract and sepiolite clay as an antioxidant film for active food packaging applications. Int. J. Biol. Macromol. 2021, 185, 451–461. [Google Scholar] [CrossRef] [PubMed]
- Gasti, T.; Hiremani, V.D.; Kesti, S.S.; Vanjeri, V.N.; Goudar, N.; Masti, S.P.; Thimmappa, S.C.; Chougale, R.B. Physicochemical and antibacterial evaluation of poly (Vinyl alcohol)/guar gum/silver nanocomposite films for food packaging applications. J. Polym. Environ. 2021, 29, 3347–3363. [Google Scholar] [CrossRef]
- Yang, W.; Ding, H.; Qi, G.; Li, C.; Xu, P.; Zheng, T.; Zhu, X.; Kenny, J.M.; Puglia, D.; Ma, P. Highly transparent PVA/nanolignin composite films with excellent UV shielding, antibacterial and antioxidant performance. React. Funct. Polym. 2021, 162, 104873. [Google Scholar] [CrossRef]
- Remiš, T.; Bělský, P.; Kovářík, T.; Kadlec, J.; Ghafouri Azar, M.; Medlín, R.; Vavruňková, V.; Deshmukh, K.; Sadasivuni, K.K. Study on structure, thermal behavior, and viscoelastic properties of nanodiamond-reinforced poly (Vinyl alcohol) nanocomposites. Polymers 2021, 13, 1426. [Google Scholar] [CrossRef] [PubMed]
- Sánchez-Silva, L.; Víctor-Román, S.; Romero, A.; Gracia, I.; Valverde, J.L. Tailor-made aerogels based on carbon nanofibers by freeze-drying. Sci. Adv. Mater. 2014, 6, 665–673. [Google Scholar] [CrossRef]
- Bueno, J.N.N.; Corradini, E.; de Souza, P.R.; Marques, V.d.S.; Radovanovic, E.; Muniz, E.C. Films based on mixtures of zein, chitosan, and PVA: Development with perspectives for food packaging application. Polym. Test. 2021, 101, 107279. [Google Scholar] [CrossRef]
- Tripathi, R.M.; Pudake, R.N.; Shrivastav, B.R.; Shrivastav, A. Antibacterial activity of poly (Vinyl alcohol)—Biogenic silver nanocomposite film for food packaging material. Adv. Nat. Sci. Nanosci. Nanotechnol. 2018, 9, 025020. [Google Scholar] [CrossRef]
- Ali, H.; Tiama, T.M.; Ismail, A.M. New and efficient NiO/chitosan/polyvinyl alcohol nanocomposites as antibacterial and dye adsorptive films. Int. J. Biol. Macromol. 2021, 186, 278–288. [Google Scholar] [CrossRef] [PubMed]
- Martínez Ferrer, M. Uso de Nuevos Materiales Antimicrobianos Sostenibles Para Envasado Alimentario [Proyecto/Trabajo fin de Carrera/Grado, Universitat Politècnica de València]. 2022. Available online: https://riunet.upv.es/handle/10251/185512 (accessed on 1 July 2022).
- Montes Hernández, A.I.; Oropeza González, R.A.; Padrón Pereira, C.A.; Araya Quesada, Y.M.; Wexler Goering, L.M.; Cubero Castillo, E.M. Películas biodegradables con propiedades bioactivas. Rev. Venez. Cienc. Y Tecnol. Aliment. 2017, 8, 057–089. Available online: https://kerwa.ucr.ac.cr/handle/10669/79335 (accessed on 3 July 2020).
- Ucak, I.; Khalily, R.; Carrillo, C.; Tomasevic, I.; Barba, F.J. Potential of propolis extract as a natural antioxidant and antimicrobial in gelatin films applied to rainbow trout (Oncorhynchus mykiss) fillets. Foods 2020, 9, 1584. [Google Scholar] [CrossRef] [PubMed]
- Qian, W.; Liu, M.; Fu, Y.; Zhang, J.; Liu, W.; Li, J.; Li, X.; Li, Y.; Wang, T. Antimicrobial mechanism of luteolin against Staphylococcus aureus and Listeria monocytogenes and its antibiofilm properties. Microb. Pathog. 2020, 142, 104056. [Google Scholar] [CrossRef] [PubMed]
Disclaimer/Publisher’s Note: The statements, opinions and data contained in all publications are solely those of the individual author(s) and contributor(s) and not of MDPI and/or the editor(s). MDPI and/or the editor(s) disclaim responsibility for any injury to people or property resulting from any ideas, methods, instructions or products referred to in the content. |
© 2023 by the authors. Licensee MDPI, Basel, Switzerland. This article is an open access article distributed under the terms and conditions of the Creative Commons Attribution (CC BY) license (https://creativecommons.org/licenses/by/4.0/).







